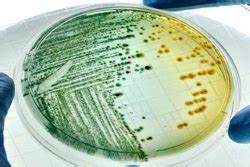

Синдром мальдигестии диета
Картинка 2: ОСНОВНЫЕ СИНДРОМЫ ПРИ ЗАБОЛЕВАНИЯХ КИШЕЧНИКА Основные синдромы
Картинка 3: Постпрандиальный дистресс-синдром: причины, характерные симптомы и
Картинка 4: ПАТОЛОГИЧЕСКАЯ ФИЗИОЛОГИЯ СИСТЕМЫ ПИЩЕВАРЕНИЯ
Картинка 5: Диета При Туннельном Синдроме — Похудение Диета Правильное Питание
Картинка 6: Диета при метаболитен синдром - кои храни са подходящи при състоянието
Картинка 7: Основные синдромы при заболеваниях кишечника - online presentation
Картинка 8: Основные синдромы при заболеваниях кишечника - online presentation
Картинка 9: Заболевания желудочнокишечного тракта Методы обследования пациента
Картинка 10: Что такое синдром Жильбера: причины болезни, лечение, диета
Картинка 11: Воспаление Кишечника Диета Стол — Похудение Диета Правильное Питание
Картинка 12: Синдром мальдигестии у детей: причины, симптомы, принципы лечения, диета
Картинка 13: Где и как лечить СИНДРОМ РАЗДРАЖЕННОГО КИШЕЧНИКА - YouTube
Картинка 14: Диета при нефротичен синдром - кои храни включва и кои изключва? | Puls.bg
Картинка 15: Синдром раздраженного кишечника ЛЕЧЕНИЕ | Как лечить СРК дома
Картинка 16: Хилак форте при поносе у взрослых и детей | medisra.ru
Картинка 17: Интересные факты о Что будет если съесть восковой карандаш
Картинка 18: Предменструальный синдром (ПМС). Ежемесячная диета - Сад и огород
Картинка 19: Основные синдромы при заболеваниях кишечника - online presentation
Картинка 20: Патофизиология пищеварения презентация, доклад
Картинка 21: Основные синдромы при заболеваниях кишечника - online presentation
Картинка 22: Ацетонемический синдром у детей - причины, симптомы, лечение, протокол
Картинка 23: Синдром Жильбера: что это? Симптомы, лечение и диета
Картинка 24: Диета при метаболитен синдром – ето правилните комбинации | Здраве.ws
Картинка 25: Основные синдромы при заболеваниях кишечника - презентация онлайн
Картинка 26: Основные клинические синдромы энтеритов Выполнила Имамутдинова Д Р
Картинка 27: Синдром Жильбера: диета и симптомы - YouTube
Картинка 28: Основные синдромы при заболеваниях кишечника - online presentation
Картинка 29: Симптоматология заболеваний кишечника - презентация онлайн
Картинка 30: Дифференциальная диагностика синдрома Мальабсорбции у детей
Картинка 31: ОСНОВНЫЕ СИНДРОМЫ ПРИ ЗАБОЛЕВАНИЯХ КИШЕЧНИКА — презентация
Картинка 32: Ошибка 429 | Метаболический синдром, Учащиеся медучилища, Товары для
Картинка 33: Ведение пациентов с заболеваниями кишечника в общей врачебной (семейной
Картинка 34: СИНДРОМ КИШЕЧНОЙ ДИСПЕПСИИ, СИНДРОМ МАЛЬДИГЕСТИИ, СИНДРОМ МАЛЬАБСОРБЦИИ
Картинка 35: Хронический панкреатит презентация, доклад
Картинка 36: Основные синдромы при заболеваниях кишечника - презентация онлайн
Картинка 37: Синдром Раздраженного Кишечника Симптомы И Лечение Диета — Похудение
Картинка 38: Диета за жени с предменструален синдром - препоръчителни храни
Картинка 39: Основные синдромы при заболеваниях кишечника - online presentation
Картинка 40: Метаболитен синдром - Лечение, диета и рискови фактори - SpiriTell
Картинка 41: патология пищеварения
Картинка 42: ОСНОВНЫЕ СИНДРОМЫ ПРИ ЗАБОЛЕВАНИЯХ КИШЕЧНИКА Основные синдромы
Картинка 43: Патология пищеварения План лекции n n n
Картинка 44: Синдром мальдигестии: причины, диагностика и лечение (диета, препараты)
Картинка 45: Патология пищеварения План лекции n n n
Картинка 46: Симптоматология заболеваний кишечника - презентация онлайн
Картинка 47: Синдром мальдигестии . - ВАШЕ ЗДОРОВЬЕ!
Картинка 48: Диета при метаболитен синдром - кои храни трябва да бъдат изключени или
Картинка 49: Синдром мальдигестии: причины, диагностика и лечение (диета, препараты)
Картинка 50: 4medic.ru - генетика / синдром мальдигестии и мальабсорбции
Картинка 51: Синдром мальдигестии :: Симптомы, причины, лечение и шифр по МКБ-10.
Картинка 52: Синдром раздраженного кишечника (СРК): причины, симптомы, питание
Картинка 53: Синдром мальдигестии: причины, диагностика и лечение (диета, препараты
Картинка 54: Синдром мальдигестии: причины, диагностика и лечение (диета, препараты)
Картинка 55: Синдром мальдигестии: причины, диагностика и лечение (диета, препараты)
Картинка 56: Синдром мальдигестии: причины, диагностика и лечение (диета, препараты)
Картинка 57: Синдром мальдигестии :: Симптомы, причины, лечение и шифр по МКБ-10.
Картинка 58: Синдром мальдигестии: причины, диагностика и лечение (диета, препараты)
Картинка 59: Синдром мальдигестии у детей: причины, симптомы, принципы лечения, диета
Картинка 60: Синдром мальдигестии: причины, диагностика и лечение (диета, препараты)

Как убрать целлюлит домашний условие

Рецепты белковой диеты от дюкана

Диеты до 5 кг

Диета почки белок

Как похудеть все есть что хочется

Диеты певзнера 5п

Диета овд 1 3

Безопасные диеты для здоровья

Диета кишечника и желудка

Как можно постройнеть без диет

Диета на куске хлеба

Диета 56 лет

Борщ диетический рецепт диета

Как пресс накачать девушки и убрать жир с живота

Ходченкова сильно похудела

Творог яблоко диета

Почему в похудел алексей макаров

Как накачать попу и убрать низ живота

Рассчитать за сколько можно похудеть
Похудеть 1300 ккал